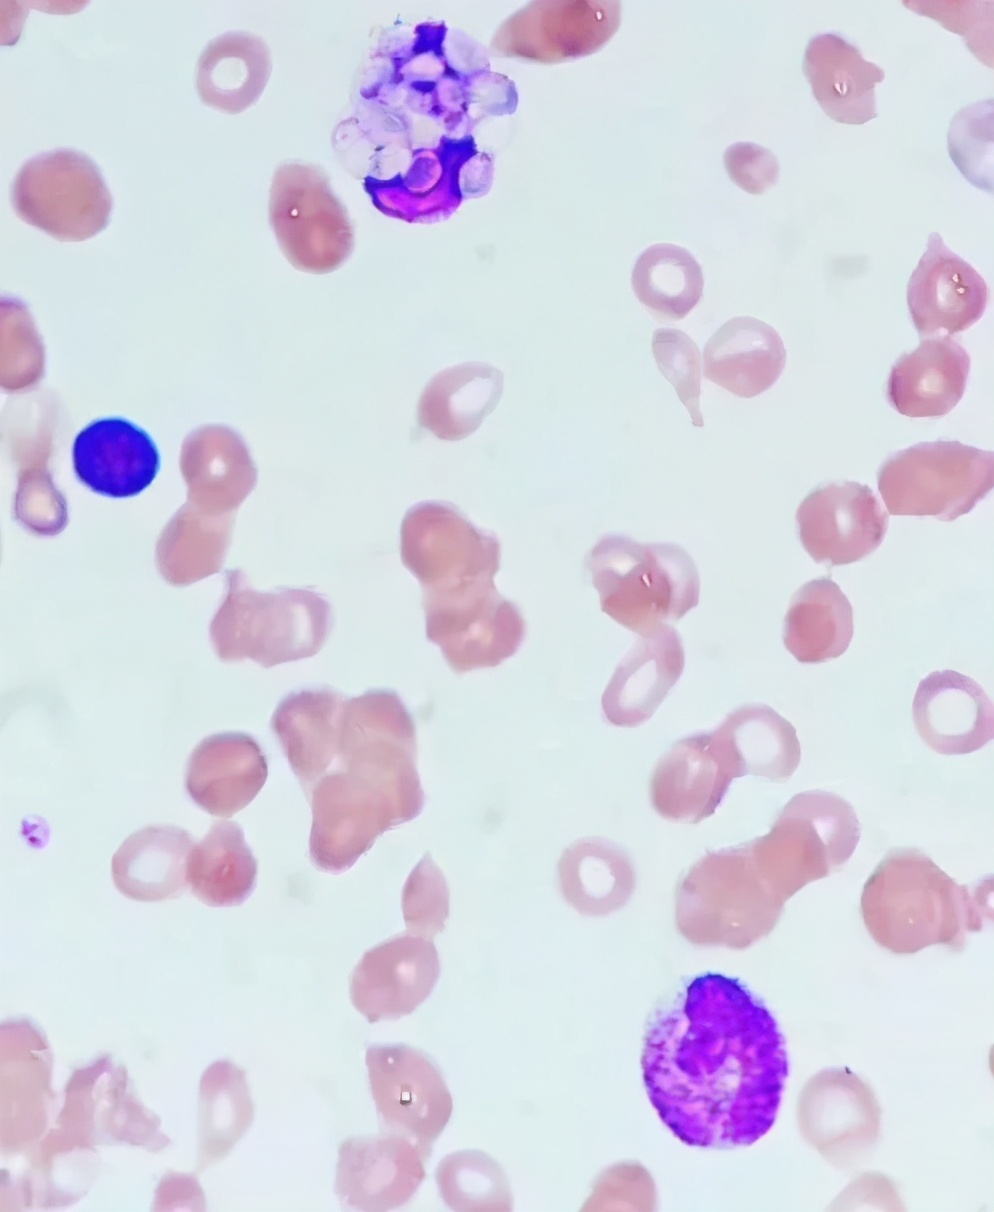
医生的恶魔，病人的死神！噬血细胞综合征来袭，生死边缘

噬血细胞性淋巴组织细胞增生症(HLH),又简称“噬血细胞综合征”,它的出现,对医生来说是恶魔,对病人来说是死神。今天跟随我们的病例,去体悟这个医者大战恶魔的曲折故事。
飞来横"疾"
五月的安徽,天刚刚燥热起来,劳动节小长假第一天,作为公交车司机的30岁的小南也迎来工作“旺季”。劳累一天之后,他发现自己发烧了,打了个寒战,穿上长外套,匆忙回家量体温,竟然有40℃。这大热的天,是感冒了吗,但他没有头痛、头晕,没有胸闷痛、气促,也没有恶心、呕吐、腹痛、腹泻。自行服用退烧药无用后,第二天,他就赶快请假去医院检查了:
查血常规示:白细胞2.53x10^9/L,中性细胞比率73.9%,红细胞计数3.47x10^12/L,血红蛋白90g/L,血小板计数83x10^9/L。尿常规蛋白质+,大便潜血+。
血生化示:白蛋白27.2g/L,甘油三酯 1.5mmol/L,谷丙转氨酶 59.4U/L,谷草转氨酶84.5U/L,碱性磷酸酶 494U/L,γ-谷氨酰转肽酶101U/L。降钙素原2.62ng/ml,血沉56mm/h, 铁蛋白测定大于2000ng/ml。
肿瘤指标示:CA125 48.57U/ml。
腹部彩超示:“肝脾肿大,胆囊壁毛糙增厚,盆腔积液”。心脏彩超未见异常。
当地医院予抗感染及对症支持治疗2天(具体方案不详),但小南的体温仍然没有降下来。2018年5月4日,转到了上级医院再次检查:
复查血常规:白细胞2.35´109/L,血小板计数70´109/L,血红蛋白79g/L,N% 70.2%。
血生化检查基本同前。
血疟原虫阴性,血弓形虫、风疹病毒、巨细胞病毒、单纯疱疹病毒、EBV、结核、肺炎支原体抗体检测均阴性。
肺CT平扫示“双肺少许炎症伴双侧胸腔少量积液;左肺上叶小结节;肝右叶钙化灶;胆囊炎;右肾小结石;脾稍大;盆腔少量积液”。
血培养回报示人葡萄球菌人亚种。
医院考虑“血流感染”,给予美罗培南+左氧氟沙星抗感染治疗,仍有高热,且出现咳嗽、咳白色粘痰,可咳出,症状无明显好转。
噬血来袭
反复近一周后,2018年5月9日,小南转诊至外院血液科。
复查血常规及肝功能较前相仿,C反应蛋白、降钙素原仍升高,铁蛋白>2000ng/ml。
自身免疫抗体阴性,G试验>1000pg/ml,血培养阴性。
完善骨髓穿刺检查,涂片示“血小板减少伴巨核细胞成熟障碍;全片见少量吞噬功能增强的网状细胞”,骨髓流式未见明显异常,骨髓液45种白血病融合基因及相关基因检测均阴性。颈部彩超示左侧颈部淋巴结肿大。
PET-CT示“1.肝脏体积增大,两侧颌下、颈部、肝门部、后腹膜多发肿大淋巴结,均伴葡萄糖代谢增高,考虑血液系统疾病可能,建议颈部淋巴结穿刺活检;2.鼻咽部局部葡萄糖代谢增高,考虑炎症可能;3.两侧上颌窦炎,两侧胸腔积液;肝右后叶钙化灶,脾大,胆囊结石可能,右肾小结石;腹盆腔积液”。
当地医院结合他的病史及辅助检查,考虑“噬血细胞综合征”,血液肿瘤不能排除。为排除常见的一些感染,当地医院先后给予比阿培南、莫西沙星、万古霉素、头孢哌酮他唑巴坦抗感染,效果不佳。期间又加了激素及免疫*制剂抑**抗炎(5.15予甲强龙40mg q12h,5.19予甲强龙40mg q8h, 5.22予地塞米松 10mg q12h,5.25予环孢素125mg bid)及其他对症支持治疗。使用激素1周后,小南觉得体温好转了几天,但不久就再次发热,每日最高可达 38℃左右,仍有咳嗽咳痰,且三系仍进行性下降,病情危重。
追踪嫌疑
2018年5月31日,小南因再次高热求医到华山医院,先至急诊,复查血常规示:白细胞0.45x10^9/L,血小板计数15x10^9/L,血红蛋白67g/L,红细胞计数2.64x10^12/L。考虑为“发热待查;噬血细胞综合征”,病情十分危险,当即收入华山医院感染科张继明教授组里治疗。
在过去的一个月里,才30岁的小南体会到了什么叫“病来如山倒”,反复的发热让他没有食欲,精神萎靡,体重都下降了20斤。入院后,张教授和时任主治的杨飞飞医生仔细地问询了他的既往病情,并根据诊疗情况绘制了一下的概况图(图1)。

图 1 患者入院前病情概略图
入院检查
体检:全身皮肤及巩膜未见黄染,有肝掌,双侧颈部可触及肿大淋巴结,约0.5cmx0.5cm,质地中等,无压痛,未见皮下出血点。肝脾可触及肿大,均约肋下5指,质地中等,有叩击痛。
血常规及生化:
血常规:血红蛋白:66g/L↓,血小板计数:14x10^9/L↓,白细胞计数:0.41x10^9/L。
肝功能:谷丙转氨酶 61U/L,谷草转氨酶 30U/L,碱性磷酸酸229U/L,γ谷氨酰转移肽酶193U/L,总胆红素23.3umol/L, 乳酸脱氢酶 554U/L,白蛋白27g/L。
DIC:APPT 34.6s, D-二聚体11.94,纤维蛋白(原)降解产物 32.1ug/ml,纤维蛋白原 2.5g/L,PT 12.2s,国际标准化比值1.07
ProBNP 1114ng/ml。
甘油三酯:1.97mmol/L。
肾功能、电解质、血糖、心肌酶谱、心肌标志物及二便常规基本正常。
感染相关:HIV/RPR/肝炎三对半/T-SPOT.TB/血隐球菌乳胶凝集试验均无明显异常。C反应蛋白 71.5mg/L↑,血沉 24mm/h, 降钙素原 2.11ng/ml。G试验 388.18pg/ml↑
肿瘤标志物:CA125:35.29U/ml↑,CA199:4.75ng/ml↑ ,NSE:24.29ng/ml↑
免疫相关:自身抗体/抗可溶性抗原/抗中性粒细胞胞浆抗体/抗心磷脂抗体均阴性。铁蛋白:>2000ng/mL。补体C3 0.724g/L↓,C4正常。血免疫球蛋白IgG 18.5g/L↑,IgM 0.35g/L↓。血λ-轻链:2.33g/L↑,尿-κ-轻链:44.1mg/L↑,尿-λ-轻链:36.5mg/L↑。淋巴细胞亚群CD六项:NK+ 2.84%↓,余正常。血免疫固定电泳无殊。
辅助检查
肺CT扫描:双肺少许炎症伴双侧胸腔积液,心包积液,随访;附见:肝脾肿大(图2)
超声波:肝脾肿大。盆腔少量积液。胆囊餐后表现。胰腺、脾脏、双肾、双侧输尿管、膀胱、后腹膜未见明显异常。左侧颈中部部分淋巴结形态较饱满。右侧颈部、双侧锁骨上、双侧腋下、双侧腹股沟区未见明显异常肿大淋巴结。
入院后,回顾小南的病程,可总结为:持续高热、肝脾肿大明显,血常规三系下降明显,铁蛋白>2000ng/mL,外周血淋巴细胞亚群分析NK细胞比例明显降低,基本符合噬血细胞综合征(hemophagocyic histiocytosis,HLH)诊断标准。

表1 国际组织细胞协会2004版HLH诊断标准
水落石出
考虑小南既往体健,为成年发病,继发性HLH可能,感染或淋巴瘤的可能性较大。为此,入院后重复行血培养检查,回报示大肠埃希菌及屎肠球菌。入院次日再次行骨穿,完善骨髓涂片、外周血涂片、骨髓流式细胞学、骨髓培养、骨髓二代测序等检查。
骨穿当日追踪涂片结果(图3),提示“骨髓象增生减低,以粒巨核系为著。骨巨噬细胞及中性粒细胞均可见吞噬大量病原体,以巨噬细胞最多见”,外周血可见中性粒细胞吞噬病原体。后骨髓流式回报未见明显异常。
骨髓活检示“十来个髓腔,造血细胞约占40%左右,巨核细胞易见,各系造血细胞未见明显异常,请结合临床。网状染色(-)”,均无淋巴瘤及其他血液系统肿瘤依据。
同时借外院首次骨穿涂片重新阅片,亦可见巨噬细胞吞噬大量类似病原体。
各项检查均为找到淋巴瘤的依据,病理结果提示:巨噬细胞吞噬大量类似病原体,这条线索瞬间让经验丰富的张教授看到了病原的苗头。于是,他立马给病理科医生打电话,请检验科里非常有经验的顾建飞老师、刘红老师一起,在显微镜下寻找“真凶”。两位老师端坐在显微镜下侦探起来,一个视野一个视野的细细查看,突然一个画面跃入眼帘:一个巨大的巨噬细胞内吞噬大量病原体,为卵圆形、直径2-4um真菌孢子结构,周围可见清晰荚膜结构。他们再把小南在外院的骨穿涂片拿来,镜下见到相同病原体——组织胞浆菌!

图3 患者入院时骨髓涂片及血涂片
由于组织胞浆菌感染必须要和引起发热、肝脾肿大且在骨髓涂片能发现相应病原体的感染性疾病进行鉴别,例如;疟疾、黑热病、球孢子菌病。
为此,我们进一步完善外周血疟原虫涂片、黑热病血清抗原检测,均阴性。最为重要的是,对小南进行血、尿组织胞浆菌抗原检测,结果均回报阳性;骨髓液及血浆二代测序(图4)示荚膜组织胞浆菌,序列数分别为5646条及190条;首次骨穿骨髓液培养(真菌瓶)3周后亦回报阳性结果,镜下鉴定为组织胞浆菌(图5)。至此,小南的诊断完全明确,考虑为“组织胞浆菌病;血流感染;噬血细胞综合征”。

图4 骨髓液二代测序报告

图5 骨髓培养示组织胞浆菌
山重水复
病因水落石出,张教授和杨医生立即调整治疗方案:停环孢素,并逐步停用丙球,地塞米松予减量,抗感染方案调整为“美罗培南1.0 q8h+万古霉素1.0 q12h+伊曲康唑200mg qd”静脉使用。即使我们如此迅速准确的对其病情做出了综合判断,然而小南后续治疗过程并不顺利,一波三折(图6)。

图6 我院治疗0-4周患者治疗方案调整及血象、体温变化
治疗1周左右随访,血常规无明显改善,激素继续减量的同时,2018年6月6日起加予两性霉素B(AMB)脂质体联合抗真菌治疗(6.6 10mg qd,6.7 20mg qd,6.8起30mg qd)。6.11复查血常规血小板仍进行性下降,仅为9x10^9/L,且肝功能损害较前加重,碱性磷酸酶428U/L↑, γ-谷氨酰转移酶267U/L↑,总胆红素39.5μmol/L↑,直接胆红素20.4μmol/L↑。考虑到AMB脂质体的肝毒性及骨髓抑制作用,6.12起暂予停用。
不好的是,D-二聚体又升高明显,并出现皮肤瘀点瘀斑,提示噬血综合征基础上合并慢性DIC可能,出凝血功能出现障碍,故加低分子肝素抗凝,地塞米松每日剂量再次加量至10mg。
后续2天随访肝功能及D-二聚体较前好转,但血常规血小板低下无明显改善,且发热症状一度好转后再次反跳。反复调动的体温和指标考虑还是原发病未控制,故6.15起再次加用两性霉素B脂质体抗真菌,并于6.19换为两性霉素B脱氧胆酸盐 25mg qd ivgtt治疗,同时停用伊曲康唑。血流感染方面,万古霉素及美罗培南治疗后患者血培养迅速转阴,因出现全身皮疹,考虑万古霉素相关,故于6.17停用。
然而让人失望的是,经过上述综合治疗20余天,患者血小板仍维持在(10-15)x10^9/L无好转,发热症状仍反反复复。
峰回路转
这时,不仅小南和家属开始焦虑不安,治疗组里每一位医生也都陷入了沉思:感染诱发噬血细胞综合征,血象缓解不明显,如何应对?
噬血细胞综合征的治疗目标除原发病的治疗外,应尽快抑制危及生命的过度的炎症反应。根据国际公认的HLH-2004方案,往往需糖皮质激素、依托泊苷(VP-16)、环孢素A等多种免疫*制剂抑**与丙球的联合使用。该病例中噬血细胞综合征虽由组织胞浆菌感染诱发,但经过充分抗真菌治疗,血象缓解极为缓慢,此时是应启动特异性免疫抑制治疗方案还是继续加强抗真菌治疗呢?
正在我们对小南的抗真菌治疗方案及效果心存疑虑,对下一步治疗一筹莫展时,检验科顾剑飞老师精心制作的一张趋势图让我们重拾信心:治疗过程中,小南的外周血涂片吞噬病原体的中性粒细胞数比例明显下降(图7),此时复查的血二代测序结果回报也显示组织胞浆菌序列数明显下降,由病初的190条下降至治疗3周时的8条。6-28抗真菌治疗4周时复查骨穿,骨髓涂片吞噬病原体数量明显减少,多以残存空荚膜结构为主。骨髓液二代测序序列数降至100条。而回归床旁,体格检查时肿大的肝脾回缩明显,由病初肋下5指缩至肋下2指。
这些证据都在告诉我们:抗真菌和抗噬血治疗有效,小南总体病情正在好转!

图7 外周血涂片吞噬病原体的中性粒细胞比例图
因此后续我们继续给予两性霉素B抗真菌及美罗培南抗感染治疗,激素亦逐步减量至每日2-4mg。治疗7周时小南体温基本控制,予停美罗培南,复查骨髓液二代测序转阴,后续单予两性霉素B抗真菌。
随访血常规,三系逐步回升,至治疗10周左右,血常规白细胞恢复至(3-4)x10^9/L,血红蛋白回升至100-120g/L,血小板升至80x10^9/L。小南一般情况恢复良好,于8月底停用两性霉素B,换用伊曲康唑静脉治疗数天,病情无反跳,8-31予出院,历时3个月(详见图8)。

图8 我院治疗第5-13周患者治疗方案调整及血象、体温变化
自出院后,小南遵医嘱以伊曲康唑200mg q12h及甲泼尼龙8mg qd口服治疗。甲泼尼龙逐渐减量,服用至2018年10月底停药。伊曲康唑口服3月,11月下旬因恶心呕吐等不良反应自行停用。
2018年9月底及11月底分别入院复查,血常规除血小板略低(80x10^9/L)外基本恢复正常,骨穿涂片偶可见吞噬空荚膜巨噬细胞。自停用后未再服用抗真菌药物,当地定期监测血常规,逐步恢复正常,电话随访,目前病情稳定,无复发。
来源:华山感染
病例编选自《翁心华疑难感染病和发热病例2019》
病例原作者|王睿莹 杨飞飞 顾剑飞 刘红 王新宇 张继明
病例编写|霍美思 李发红
#超能健康团# #医师报超能团#
免责声明:转载本文系出于传递信息之目的,版权归原作者所有。我们已在显著位置注明来源和作者,如不希望被转载的媒体或个人,请与小编联系进行处理。
我们对所转载文中的观点保持中立,所载内容不作为治疗依据。